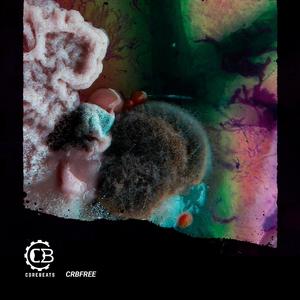
My Search

Introspection
热门歌曲
-
Introspection 1.83 MB 02:00
-
Introspection 6.55 MB 07:09
-
Introspection 4.96 MB 05:24
-
Introspection 3.89 MB 04:15
-
Introspection 5.84 MB 06:22
-
Introspection 6.14 MB 06:42
-
Introspection 5.59 MB 06:06
-
Introspection 2.85 MB 03:06
-
Introspection 6.81 MB 07:25
-
Introspection 2.85 MB 03:06
-
Introspection 3.19 MB 03:29
-
Introspection 2.93 MB 03:12
-
Introspection、Santiago guzman ramirez 6.6 MB 07:12
-
Introspection 7.33 MB 08:00
-
Introspection 5.91 MB 06:27
-
Introspection 1.55 MB 01:41
-
Introspection 1.85 MB 02:01
-
Introspection 6.91 MB 07:32
-
Introspection 4.23 MB 04:36
-
Introspection 3.7 MB 04:02
-
Introspection 5.81 MB 06:21
-
Introspection 1.77 MB 01:56
-
Introspection 2.59 MB 02:49
-
Introspection 4.6 MB 05:01
-
Introspection 3.6 MB 03:55
-
Introspection 3.16 MB 03:27
-
Introspection 4.12 MB 04:30